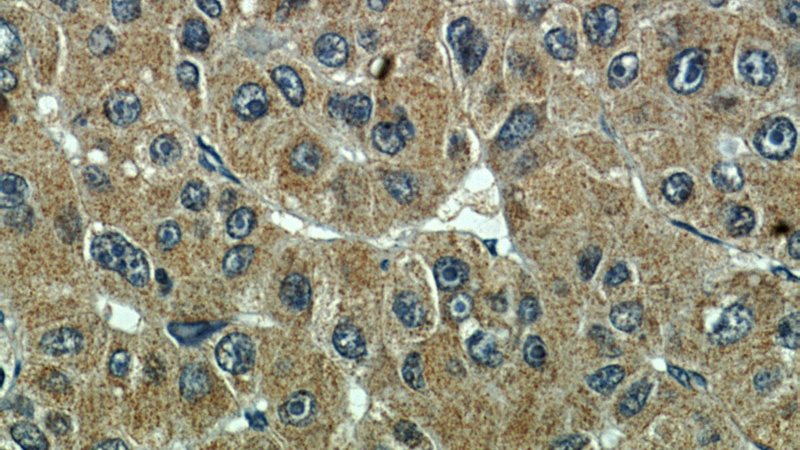
Immunohistochemical of paraffin-embedded human liver cancer using Catalog No:117299(Tubulin-Alpha antibody) at dilution of 1:100 (under 40x lens)

-
Product Name
alpha Tubulin antibody
- Documents
-
Description
alpha Tubulin Mouse Monoclonal antibody. Positive IP detected in HeLa cells. Positive WB detected in multi-cells, A431 cells, HeLa, HeLa cells, L02 cells, SW 1990 cells. Positive FC detected in HeLa cells. Positive IF detected in HepG2 cells, Hela cells, MCF-7 cells. Positive IHC detected in human liver cancer tissue, human testis tissue, human tonsillitis tissue. Observed molecular weight by Western-blot: 52 kDa
-
Tested applications
ELISA, IHC, FC, IP, IF, WB
-
Species reactivity
Human,Mouse,Rat; other species not tested.
-
Alternative names
alpha Tubulin antibody; Alpha tubulin ubiquitous antibody; TUBA1B antibody; tubulin antibody; Tubulin alpha antibody; tubulin antibody; alpha 1b antibody
- Immunogen
-
Isotype
Mouse IgG2b
-
Preparation
This antibody was obtained by immunization of alpha Tubulin recombinant protein (Accession Number: NM_006082). Purification method: Protein A purified.
-
Clonality
Monoclonal
-
Formulation
PBS with 0.02% sodium azide and 50% glycerol pH 7.3.
-
Storage instructions
Store at -20℃. DO NOT ALIQUOT
-
Applications
Recommended Dilution:
WB: 1:2000-1:10000
IP: 1:500-1:5000
IHC: 1:50-1:500
IF: 1:20-1:200
-
Validations

Western blot analysis of alpha-tubulin in various tissues and cell lines using Proteintech antibody Catalog No:117299 at a dilution of 1:10000.

Western blot of Hela cell with anti-Tubulin-Alpha (Catalog No:117299) at various dilutions.

Immunofluorescent analysis of HepG2 cells using Catalog No:117299(Tubulin-Alpha Antibody) at dilution of 1:100 and Alexa Fluor 488-congugated AffiniPure Goat Anti-Mouse IgG(H+L)

IP Result of anti-Tubulin-Alpha (IP:Catalog No:117299, 5ug; Detection:Catalog No:117299 1:1000) with HeLa cells lysate 2800ug.
Immunohistochemical of paraffin-embedded human liver cancer using Catalog No:117299(Tubulin-Alpha antibody) at dilution of 1:100 (under 40x lens)

Immunofluorescent analysis of HepG2 cells using Catalog No:117299(Tubulin-Alpha Antibody) at dilution of 1:100 and Alexa Fluor 488-congugated AffiniPure Goat Anti-Mouse IgG(H+L)

1X10^6 HeLa cells were stained with 0.2ug Tubulin-Alpha antibody (Catalog No:117299, red) and control antibody (blue). Fixed with 90% MeOH blocked with 3% BSA (30 min). FITC-Goat anti-Mouse IgG with dilution 1:100.

Immunohistochemical of paraffin-embedded human liver cancer using Catalog No:117299(Tubulin-Alpha antibody) at dilution of 1:100 (under 10x lens)
-
Background
There are five tubulins in human cells: alpha, beta, gamma, delta, and epsilon. Tubulins are conserved across species. They form heterodimers, which multimerize to form a microtubule filament. An alpha and beta tubulin heterodimer is the basic structural unit of microtubules. The heterodimer does not come apart, once formed. The alpha and beta tubulins, which are each about 55 kDa MW, are homologous but not identical. Alpha, beta, and gamma tubulins have all been used as loading controls. Tubulin expression may vary according to resistance to antimicrobial and antimitotic drugs. This antibody recognizes Tubulin Alpha only.
-
References
- Yunlei Z, Zhe C, Yan L. INMAP, a novel truncated version of POLR3B, represses AP-1 and p53 transcriptional activity. Molecular and cellular biochemistry. 374(1-2):81-9. 2013.
- D'Alfonso TM, Hannah J, Chen Z, Liu Y, Zhou P, Shin SJ. Axl receptor tyrosine kinase expression in breast cancer. Journal of clinical pathology. 67(8):690-6. 2014.
- Zhu M, Chen Q, Liu X. lncRNA H19/miR-675 axis represses prostate cancer metastasis by targeting TGFBI. The FEBS journal. 281(16):3766-75. 2014.
- Liu D, Wang W, Cai X. Modulation of amylose content by structure-based modification of OsGBSS1 activity in rice (Oryza sativa L.). Plant biotechnology journal. 12(9):1297-307. 2014.
- Luccarini I, Grossi C, Rigacci S. Oleuropein aglycone protects against pyroglutamylated-3 amyloid-ß toxicity: biochemical, epigenetic and functional correlates. Neurobiology of aging. 36(2):648-63. 2015.
- Li X, Liu Y, Chen W. TOP2Ahigh is the phenotype of recurrence and metastasis whereas TOP2Aneg cells represent cancer stem cells in prostate cancer. Oncotarget. 5(19):9498-513. 2014.
- Lu M, Wu J, He F. Cell expression patterns of CD147 in N-diethylnitrosamine/phenobarbital-induced mouse hepatocellular carcinoma. Journal of molecular histology. 46(1):79-91. 2015.
- Zhang L, Feng D, Tao H, DE X, Chang Q, Hu Q. Increased stathmin expression strengthens fear conditioning in epileptic rats. Biomedical reports. 3(1):28-32. 2015.
Related Products / Services
Please note: All products are "FOR RESEARCH USE ONLY AND ARE NOT INTENDED FOR DIAGNOSTIC OR THERAPEUTIC USE"
